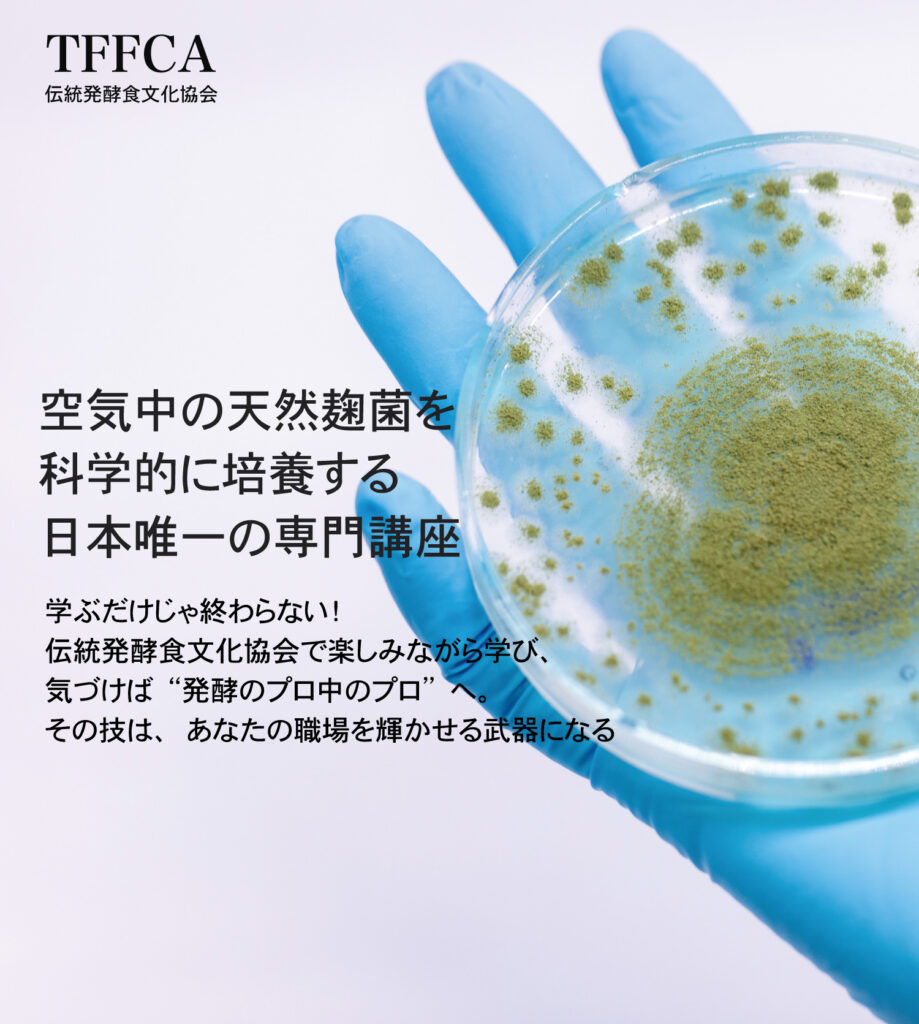
天然麹菌 培養士 伝統発酵食文化協会

唯一無二の「天然菌」講座

日本唯一、科学的に学べます。
今の麹は遺伝子組み換えであることを知っていますか?
天然の力!驚きに満ちています。時代を超え、技は継承されています。
実践講座
ただの座学ではありません。手で触って肌で感じることがとても大事です。天然麹はすぐ手に入るものではなく、じっくり時間をかけて待つことで素晴らしい価値が手に入ります。
日本唯一の天然麹菌培養学
天然菌を用いた非加熱・米100%のヨーグルトをはじめ、従来の常識を覆す天然味噌や天然醤油の作り方、さらには他では類を見ない「天然麹カビ学」まで、深く体系的に学ぶことができます。市販の種菌に頼る必要はありません。空気中に存在する菌を活かし、いつでもどこでも自ら培養できる一生ものの技術を習得いただけます。


Our Winning Award

Envato Design of The Week

Awards Site of The Year

Best Customer Support

Top Selling Premium Item

発酵を楽しく学べる!!!
全国から参加されるくらい日本唯一の専門コースから一般の方も無料で参加できる講演会までたくさん参加される参加者と楽しく発酵を学べる場所です。
会員登録をすると特典
会員になりますと様々な特典かありますが、無料講演会に参加できるのはもちろん、会員限定講座などに参加できます。

認定講師制度
当協会では専門コースを修了した受講者は、認定講師会員になることができます。認定講師になって一緒に伝統発酵を広めましょう。
日本唯一「天然麹培養士」専門養成講座


発酵を楽しく学びましょう!
“ 講座に参加して、本当に良かったと感じています。 これまで当たり前だと思い、疑うことなく信じていた情報が、実は誤っていたと知り、大変驚きました。SNS上の情報の影響力の大きさと怖さを改めて実感しました。 非常に勉強になる内容でしたので、ぜひまた参加させていただきたいと思います。貴重な講座を本当にありがとうございました。
山下
一般会員“ まさか味噌が発酵食ではない場合があるという事実を知り、大きな衝撃を受けました。 正しい知識を学ばなければ、企業のマーケティングに振り回されてしまうことを痛感しました。 今回の講座で発酵の本質を学ぶことができ、心より感謝しております。ありがとうございました。 "
木本
一般会員“麹が遺伝子組み換えである可能性について、冷静に考えれば単一菌であることは明白だと感じました。 一定の温度と湿度が整わなければ失敗することを踏まえると、天然菌の理解がいかに重要かを実感しています。 今後は正しい知識として天然菌について学び、まだ知らない方々にも伝えていきたいと思います。 貴重な講座を本当にありがとうございました。."
渡辺
一般会員“ これまでメジュを作ってきましたが、青カビや黒カビが発生するたびに、「本当に安全なのか」「食べても良いのか」と疑問を感じていました。 今回、先生の講座を受講し、顔カビの危険性や、なぜ食べてはいけないのかを明確に理解することができました。 「伝統」という言葉だけを信じて学んでいる友人たちにも、早く正しい知識を伝えなければならないと強く感じています。 ”
山田
一般会員


























